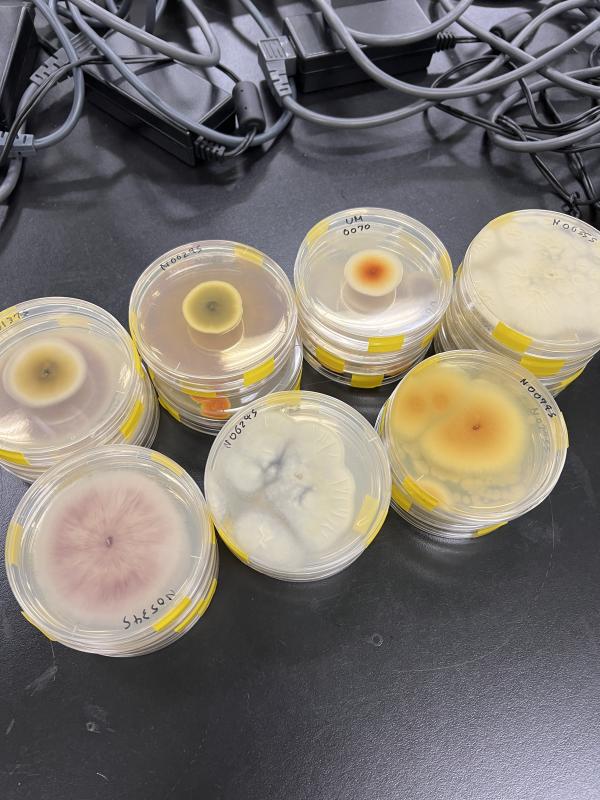

7月22日(土)、昨年に引き続き舳倉島に行ってきました。
渡りの時期ではないので、今回もウミネコ以外にはほとんど会えませんでしたが、地質、植生、海浜動植物等の観察を4時間半で行ってきました。

輪島港より定期船の希海に乗船。
波は最初穏やかでしたが、外海はそれなりに揺れました。

中央部南側の伊勢神宮
タブ、モチノキ、トベラ等を観察しました。
島は対馬暖流の影響でバイオームは照葉樹林。
写真はヘグラマイマイを探している様子です。



島の北東端
潮間帯にはカメノテ、フジツボやカサガイなどがはりついています。
今年はアオウミウシとウメボシイソギンチャクを観察することができました。
ウミウチワ等の海藻類も確認できました。



島ではコオニユリのオレンジ、ハマナデシコの濃いピンク、ナミキソウのブルーがいずれも鮮やかでした。

北西海岸の龍神池
ドロイ群落を確認できました。
イトトンボや、種は不明ですが大型のトンボが多数飛翔していました。
6月2日(金)金沢工業大学にて、実施されました。「物理部」「化学部」「生物部」が統合され、「自然科学部」となり、初めての行事でした。
私たちは「バイオと化学で新型コロナウィルス増殖阻害物質を創る」とテーマのもと、1日をかけて、専門的な内容はもちろん、器具の操作方法や、菌の培養など、日頃の授業ではできないような体験をすることができました。何かを研究するときには、失敗はつきもので、むしろ、失敗を分析することで次につながるというや、大学レベルの実験は1日単位であるということに驚きましたが、今後、私たちも様々な実験や研究をする上での教訓になりました。
これからも、このような行事を通して、自然科学を探究する力を養っていきたいと思います。

本校物理部が運営する「泉丘サイエンスグランプリ」と京都市立堀川高校「探究道場」とのコラボ企画である
『矛盾(ほこたて)プロジェクト-最強の盾を作ろう-』
を12/17(土)に県内から中学生17名を招いて実施しました。
物理部は以前からサイエンスグランプリなどを通してイベントの企画や運営を数多く行っており、小中学生対象の実験教室も何度か実施しています。今回はそのノウハウを活かして、堀川高校とオンラインでつなぎながら、同時進行で実施する試みをしてみました!
発砲スチロールで最強の盾作りに挑戦している中学生たちを、物理部部長の池田くん(2年)をはじめとする物理部員8名がサポートしつつ、とっても楽しい会になりました!
きっとこの中学生の中から、次世代の本校物理部員も現れてくれるでしょう♪ この記事をご覧の小中学生の皆さん、次回は是非ご参加ください!

引き続き物理部は、外部での小中学生向けの科学イベント等にも参加していきたいと考えています。もし、ご協力できることがあれば、金沢泉丘高校までご連絡をください!